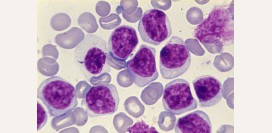
Хронический миелолейкоз - причины, симптомы, диагностика, лечение и прогноз
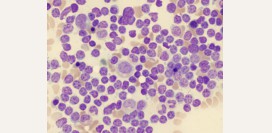
Хронический лимфолейкоз – симптомы, причины, лечение, прогноз.

Содержание статьи:
Лимфосаркомы - группа злокачественных заболеваний крови, с быстро прогрессирующим течением и возможностью развития патологического процесса в любом органе. В основе болезни лежит размножение опухолевых клеток крови (злокачественные лимфоциты).
В большинстве случаев анализ периферической крови без специфических изменений.
Возможны:
Первичный очаг опухоли может развиться в любом органе (лимфатические узлы, кишечник, желудок, селезенка, миндалины, кости, кожа и др.).
Местные симптомы
Причина: Увеличенные узлы могут сдавить трахею, бронхи, верхнюю полую вену.
При развитии лимфосаркомы в миндалинах:
В I и II стадии лечение проводят по схемам химио и радиотерапии в определенной последовательности:
1. Химиотерапия: золотой стандарт схема препаратов ЦДОП (циклофосфамид, доксарубицин, онкавин, преднизолон). 3 курса по 5 дней. Курс повторяют каждые 3-4 недели.
2. Радиотерапия гамма излучением. Облучают место первого проявления заболевания. Суммарная доза облучения 42-46 Грей на протяжении 6 недель.
3. Снова 3 курса химиотерапии по схеме.
В III и IV стадии:
Только химиотерапия от 6 до 17 курсов по схеме ЦДОП или ЦОП (циклофосфамид, онкавин, преднизолон).
В последнее время в комбинации с химиотерапией применяют новый препарат МабТера (моноклональные антитела). Особенность: действует только на опухолевые лимфоциты.
Лабораторные показатели
Общий анализ кровиВ большинстве случаев анализ периферической крови без специфических изменений.
Возможны:
- Гемоглобин: умеренно снижен
- Эритроциты: снижены
- Ретикулоциты: повышены
- СОЭ: повышена
- Лейкоциты: повышены незначительно
- Лимфоциты: повышены
- в терминальных стадиях определяются опухолевые клетки в периферической крови
Симптомы
Картина симптомов зависит от места, с которого началось развитие заболевания.Первичный очаг опухоли может развиться в любом органе (лимфатические узлы, кишечник, желудок, селезенка, миндалины, кости, кожа и др.).
Местные симптомы
- В 50% случаев первыми поражаются лимфатические узлы (шейные, подмышечные,паховые и др.). Вначале, увеличивается один узел, затем опухолевый процесс распространяется на соседние узлы. Они безболезненны, не спаяны с кожей, плотно-эластичной консистенции, увеличиваясь, сливаются в большие группы.
- Кашель
- Одышка
- Отечность лица
- Расширение вен на лице и шее
При развитии лимфосаркомы в миндалинах:
- Боли в горле при глотании
- Изменение тембра голоса
- Боли в животе
- Вздутие
- Тошнота, рвота
- Задержка стула или диарея
- Усталость
- Снижение аппетита
- Повышение температуры, жар
- Потливость по ночам
- Быстрая потеря веса
- Повышенная утомляемость
Причина лимфосарком
Появление злокачественной клетки крови в результате генетических мутаций. В последующем из неё происходит размножение множества опухолевых клонов. Мутации могут быть вызваны ионизирующим излучением, химическими веществами, вирусами и др.Как лечить?
Тактика лечения зависит от первичного очага лимфосаркомы, её варианта и стадии.В I и II стадии лечение проводят по схемам химио и радиотерапии в определенной последовательности:
1. Химиотерапия: золотой стандарт схема препаратов ЦДОП (циклофосфамид, доксарубицин, онкавин, преднизолон). 3 курса по 5 дней. Курс повторяют каждые 3-4 недели.
2. Радиотерапия гамма излучением. Облучают место первого проявления заболевания. Суммарная доза облучения 42-46 Грей на протяжении 6 недель.
3. Снова 3 курса химиотерапии по схеме.
В III и IV стадии:
Только химиотерапия от 6 до 17 курсов по схеме ЦДОП или ЦОП (циклофосфамид, онкавин, преднизолон).
В последнее время в комбинации с химиотерапией применяют новый препарат МабТера (моноклональные антитела). Особенность: действует только на опухолевые лимфоциты.